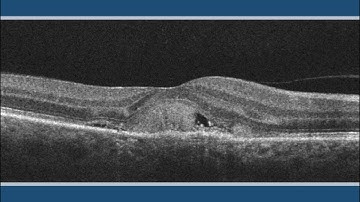
Subretinal Hyperreflective Material (SHM)

⬇ DOWNLOAD NOW
Kalau muncul iklan pop-up, tutup lalu klik tombol kembali
Download lagu ProMetric® Software - Segmented Cross-Section Tool: Evaluating Inner-Symbol Luminance Uniformity secara gratis hanya untuk keperluan promosi. Dukung artis favorit kamu dengan membeli musik original di iTunes atau platform resmi lainnya.
 ILM Luminance Meter: Road Testing Made Fast with CIE 140
ILM Luminance Meter: Road Testing Made Fast with CIE 140
 A2GLÜK luminance measuring
A2GLÜK luminance measuring
Subretinal Hyperreflective Material (SHM)
Subretinal Hyperreflective Material (SHM)
 Auto-POI Training, Part 1 - Getting Started: Defining Points of Interest
Auto-POI Training, Part 1 - Getting Started: Defining Points of Interest
 Auto-POI Training, Part 5 - Setting Global Thresholds for Color
Auto-POI Training, Part 5 - Setting Global Thresholds for Color
 Analysis of Non-uniformity of LED Display Video Screen Walls
Analysis of Non-uniformity of LED Display Video Screen Walls
 ExamVision NEW colours for Panto frame
ExamVision NEW colours for Panto frame
 Route and Verify Multicore Wires Together
Route and Verify Multicore Wires Together